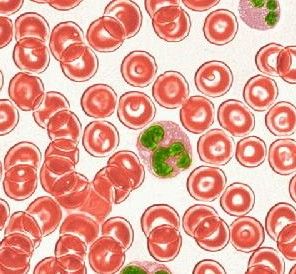
老年人高鈉血症 老年人高鈉血症

症狀體徵
輕度高鈉血症可表現為非特異的衰弱、頭痛、易激惹或嗜睡等症狀,嚴重高鈉血症(血鈉>150mmol/L)則可出現震顫、抽搐、驚厥,或遲鈍、木僵、昏迷。其臨床體徵主要為容量缺失和脫水,如體重減輕、皮膚彈性差、黏膜乾燥和體位性低血壓。此外,尚有原發疾病的表現如明顯多尿(尿崩症)、高熱(感染)等,若高鈉系注射高滲鹽水所致者,則有高血壓、呼吸困難和咳嗽等心衰表現。
用藥治療
1.病因治療 病因明確者應採取針對性的治療,以制止水分繼續丟失。
2.補充水分 能口服補充者,儘量口服補充;靜脈補充常需低張液體。單純性脫水者,可用5%葡萄糖水,必要時加小量胰島素;合併失鹽者,可補3/4總補液量的5%葡萄糖水和1/4的生理鹽水;合併低血壓者,宜先補充生理鹽水,以改善組織灌注。血鈉降低不宜過快以免發生腦水腫,通常血鈉下降每小時不應快於2mmol/L,以在48h將血鈉降到接近正常水平為宜。
飲食保健
宜清淡為主,多吃蔬果,合理搭配膳食,注意營養充足。適當控制鈉和水的攝入,使血鈉水平維持在正常範圍。
預防護理
補液時,還應注意補鉀和尿量,對於有心臟疾病者,應特別謹慎以防心力衰竭。
病理病因
主要原因是攝水減少、失水增加,水丟失超過鈉丟失,如因隱性失水的高熱和呼吸深快,滲透性水樣腹瀉的胃腸疾病,未經控制的糖尿病所致的滲透性利尿。年老體弱、反應遲鈍、口渴感減弱等,在老年人常見;中樞性尿崩症,或因慢性腎病、高鈣血症、低鉀血症等所致的獲得性外周性尿崩症,在老年人亦可見;因鈉輸入過多者少見,常因治療不當所致。
疾病診斷
1.尿崩症 又稱垂體性尿崩症,是垂體後葉分泌ADH缺乏,其發病原因不明。臨床特徵為煩渴、多飲、多尿(日尿量可達5~10L)、尿相對密度低(1.001~1.005)、尿滲透壓低(50~200mmol/L)。臨床上又分為特發性尿崩症和繼發性尿崩症,後者是由於下丘腦垂體的腫瘤,腦部創傷、手術、炎症引起,當病變累及下丘腦口渴中樞而喪失口渴感時,往往因不能及時補充水分,而致嚴重脫水,甚至死亡。當懷疑尿崩症時應做禁飲加壓素試驗及血漿ADH測定以明確診斷,必要時應做頭顱CT和X線檢查以排除垂體腫瘤。
2.腎性尿崩症 為遺傳性疾病,臨床表現與尿崩症相似。患者多為男孩,出生後數月發病。此病注射加壓素後尿量不減,尿比重亦不增加,血漿ADH濃度明顯升高,可與垂體性尿崩症相鑑別。
3.間質性腎炎及腎濃縮功能嚴重障礙 引起的病因眾多,除腎盂腎炎外,藥物(鋰鹽、地美環素等)、低鉀、高鈣、尿路梗阻、痛風等都可引起本病。表現高鈉血症,多尿,脫水。根據病史,腎功能檢查及血清電解質測定可鑑別診斷。
4.糖尿病高滲性昏迷 多見於老年患者,發病前有輕度糖尿病甚至不知有糖尿病,常因感染,套用利尿劑或糖皮質激素等誘發。臨床表現除有高鈉血症、脫水外主要為神經系統症狀,如神志不清,嗜睡、偏癱、失語、抽搐等,易與腦血管意外相混淆。本症應與滲透性利尿劑所致的高鈉血症鑑別。
5.特發性高鈉血症 病因不明,臨床少見。其診斷標準為:①持續性高鈉血症;②無明顯脫水和口渴感;③禁飲時尿液變為高滲,說明機體仍有分泌ADH的能力;④腎小管對ADH仍有反應,套用加壓素時可致水瀦留。有人認為本病為ADH釋放“閾值升高”征症候群。
此外,還應與原發性醛固酮症、皮質醇增多症等內分泌性疾患相鑑別。
檢查方法
實驗室檢查:
實驗室檢查除血鈉水平升高外,尚可發現血細胞比容、血清滲透壓、BUN和Cr水平增高等血液濃縮改變。由於老年人腎濃縮功能下降,其尿滲透壓常無明顯升高。
其他輔助檢查:
合併心衰和水腫時,心電圖可見異常表現。
併發症
並發高血壓、心力衰竭或肺水腫、驚厥、昏迷等。
預後
取決於原發病因,如糖尿病高滲昏迷病死率高。
發病機制
血鈉過高導致血液高滲狀態,使細胞內脫水,特別是腦細胞脫水,引起一系列神經系統症狀。